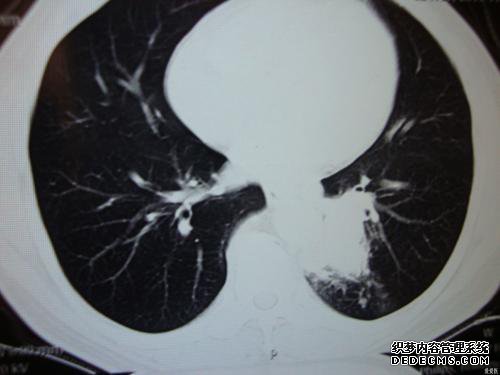

有5个答案,可以显示全部
回答
CT大目标,这应该是大面积颅内出血,这个应该及时治疗,希望您健康
回答
所描述的情况不安全。应结合患者的临床症状,白色阴影应为炎症或气体。2015-11-16
回答
考虑到小叶性肺炎,对病史和其他临床试验的结果进行综合分析,通常采用抗生素进行抗生素治疗
回答
肺部疾病主要分为三种类型。第一类是传染性肺部疾病,包括肺炎(咳嗽,咳嗽,发烧,胸闷,疲劳,呼吸急促等),肺结核(通常是咳嗽,下午咳嗽和血液和低热,疲倦,盗汗,食欲不振等)。症状),支气管扩张(常见症状是咳嗽和长期血),肺曲霉菌病(大多无全身症状,有些He血,咳嗽第二类是肺肿瘤,包括肺癌)(中老年人,头发,刺激性咳嗽,充血,胸痛,体重减轻,嗓音,酒精,咳嗽等),肺转移(身体其他部位)它们大多数是无症状的,有肺炎的假性肺炎(大多数患者),有肺炎病史,大多数肺部没有症状,可能不容易与肺癌区分开;第三类是,患有先天性肺发育不良,主要在肺囊肿中(男孩和年轻人中更多)一般),肺错构瘤(通常无症状),肺隔离(先天性肺)的发展可能包括张。
2015-11-16
回答
首先要考虑的是肺炎,但应观察到阴影和其他硬化性病变(如结核和肿瘤)的具体位置和形状。
建议根据需要执行CT扫描以及改善和支气管镜检查。
2015-11-16
上一篇:[杉本X Gate中国供应只卖日本ESCO你好钳EA525AH
下一篇:没有了